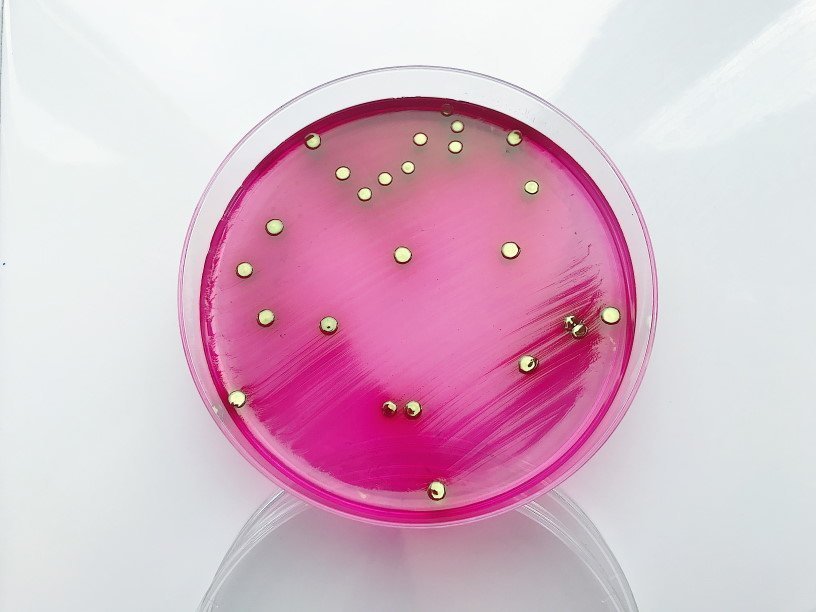

Екатерина Беленко: Промикробы: Зона комфорта
Мы, труженики медицинской микробиологии, работаем с микроорганизмами, любимая температура которых — заветные 36,6 градусов. Но вкусы других микроорганизмов весьма специфичны. А учитывая, что вся наша планета плотным слоем покрыта микробами, то сложно даже представить, до какой степени они бывают разные. Один грамм почвы в среднем содержит 40 миллионов бактериальных клеток, а в миллилитре свежей воды можно найти миллион клеток бактерий. Биомасса всех бактерий превышает суммарную биомассу животных и растений. Они играют важную роль в круговороте питательных веществ — например, именно бактерии осуществляют фиксацию атмосферного азота. Больше никто не может выполнять эту важнейшую для всей планеты миссию.
Экстремофильные бактерии, обитающие рядом с горячими гидротермальными источниками, вырабатывают энергию из нерастворимых соединений, таких как сероводород и метан. Грубо говоря, они едят сероводород! Да не просто едят, а на глубине больше 2000 метров и при температуре больше 100 градусов, создавая таким образом самую глубокую часть биосферы.
У бактерий наблюдается колоссальное разнообразие видов метаболизма. Традиционно таксономия бактерий строилась именно на основе их метаболических особенностей, но сейчас в моде геномные последовательности.
Бактерии получают энергию двумя способами: поглощая свет в ходе фотосинтеза или окисляя химические соединения, — этот процесс называется хемосинтез. Хемотрофы (ну, вот эти ребята, которые практикует хемосинтез) используют в качестве источника энергии химические вещества, перенося электроны с донора на акцептор в ходе окислительно-восстановительной реакции. Высвобождающаяся при этой реакции энергия далее используется для нужд метаболизма. В зависимости от того, какое вещество используется как донор электронов, хемотрофы подразделяются ещё на несколько групп. Бактерии, использующие неорганические вещества, такие как водород, угарный газ или аммиак, называются литотрофами, а бактерии, окисляющие органические соединения, называются органотрофами. Бактерий также классифицируют в зависимости от веществ, выступающих акцепторами электронов. У аэробов акцептором электронов выступает кислород, а анаэробы используют для этого другие соединения, такие как нитрат, сульфат и углекислый газ.
Понимаю, что звучит очень страшно и запутанно, но я перечислила эту кучу умных слов лишь для того, чтобы еще чуточку очаровать вас микромиром. Они все такие разные, в отличие от нас, любителей картошки фри с сырным соусом. Красавицу на фотографии вы уже отлично знаете — кишечная палочка. Взглянув на нее сквозь призму сегодняшней темы, мы узнаем, что Escherichia coli — хемоорганотроф. Вот так-то!